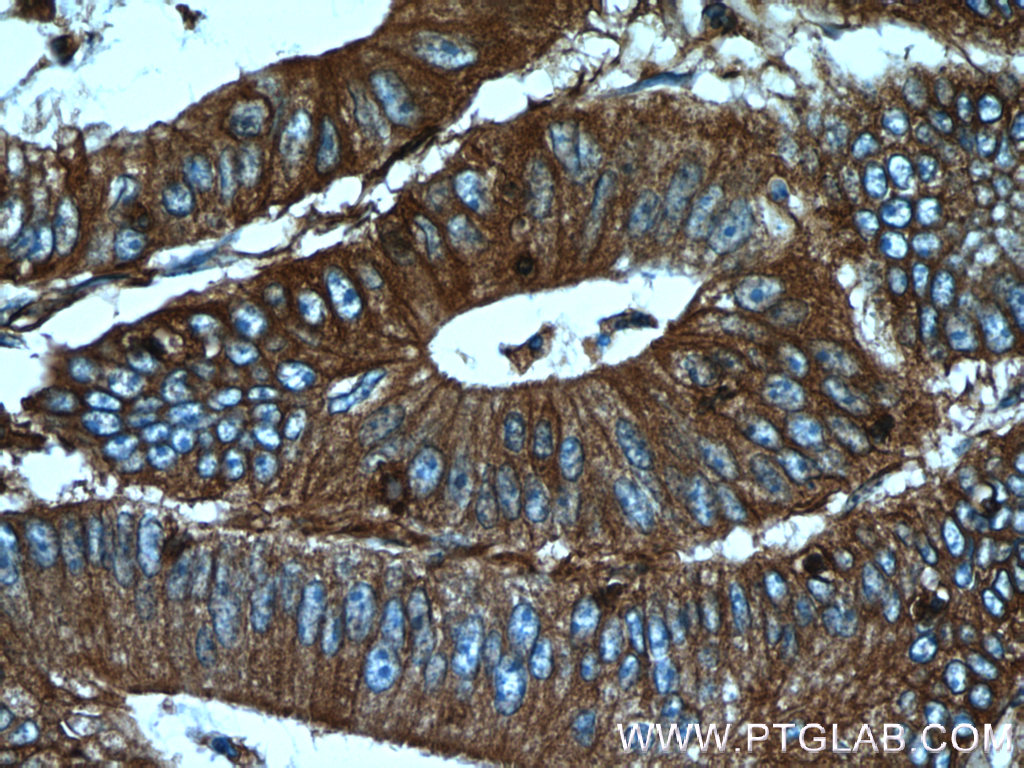

验证数据展示
经过测试的应用
| Positive WB detected in | HeLa cells, A549 cells |
| Positive IP detected in | HeLa cells, HEK-293 cells |
| Positive IHC detected in | human colon cancer tissue, human breast cancer tissue, human colon tissue, human ovary tumor tissue Note: suggested antigen retrieval with TE buffer pH 9.0; (*) Alternatively, antigen retrieval may be performed with citrate buffer pH 6.0 |
| Positive IF/ICC detected in | HeLa cells |
| Positive FC (Intra) detected in | HeLa cells |
推荐稀释比
| 应用 | 推荐稀释比 |
|---|---|
| Western Blot (WB) | WB : 1:1000-1:4000 |
| Immunoprecipitation (IP) | IP : 0.5-4.0 ug for 1.0-3.0 mg of total protein lysate |
| Immunohistochemistry (IHC) | IHC : 1:50-1:500 |
| Immunofluorescence (IF)/ICC | IF/ICC : 1:50-1:500 |
| Flow Cytometry (FC) (INTRA) | FC (INTRA) : 0.40 ug per 10^6 cells in a 100 µl suspension |
| It is recommended that this reagent should be titrated in each testing system to obtain optimal results. | |
| Sample-dependent, Check data in validation data gallery. | |
产品信息
10853-1-AP targets Palladin in WB, IHC, IF/ICC, FC (Intra), IP, COIP, ELISA applications and shows reactivity with human, mouse samples.
| 经测试应用 | WB, IHC, IF/ICC, FC (Intra), IP, ELISA Application Description |
| 文献引用应用 | WB, IHC, IF, IP, COIP |
| 经测试反应性 | human, mouse |
| 文献引用反应性 | human, mouse, rat |
| 免疫原 |
CatNo: Ag1288 Product name: Recombinant human PALLD,palladin protein Source: e coli.-derived, PGEX-4T Tag: GST Domain: 127-510 aa of BC013867 Sequence: APFFEMKLKHYKIFEGMPVTFTCRVAGNPKPKIYWFKDGKQISPKSDHYTIQRDLDGTCSLHTTASTLDDDGNYTIMAANPQGRISCTGRLMVQAVNQRGRSPRSPSGHPHVRRPRSRSRDSGDENEPIQERFFRPHFLQAPGDLTVQEGKLCRMDCKVSGLPTPDLSWQLDGKPVRPDSAHKMLVRENGVHSLIIEPVTSRDAGIYTCIATNRAGQNSFSLELVVAAKEAHKPPVFIEKLQNTGVADGYPVRLECRVLGVPPPQIFWKKENESLTHSTDRVSMHQDNHGYICLLIQGATKEDAGWYTVSAKNEAGIVSCTARLDVYTQWHQQSQSTKPKKVRPSASRYAALSDQGLDIKAAFQPEANPSHLTLNTALVESEDL 种属同源性预测 |
| 宿主/亚型 | Rabbit / IgG |
| 抗体类别 | Polyclonal |
| 产品类型 | Antibody |
| 全称 | palladin, cytoskeletal associated protein |
| 别名 | PALLD, PALLD,palladin, CGI 151, CGI-151, KIAA0992 |
| 计算分子量 | 1383 aa, 151 kDa |
| 观测分子量 | 95 kDa, 140 kDa |
| GenBank蛋白编号 | BC013867 |
| 基因名称 | palladin |
| Gene ID (NCBI) | 23022 |
| RRID | AB_2158782 |
| 偶联类型 | Unconjugated |
| 形式 | Liquid |
| 纯化方式 | Antigen affinity purification |
| UNIPROT ID | Q8WX93 |
| 储存缓冲液 | PBS with 0.02% sodium azide and 50% glycerol, pH 7.3. |
| 储存条件 | Store at -20°C. Stable for one year after shipment. Aliquoting is unnecessary for -20oC storage. |
背景介绍
Palladin is an actin associated protein serving as a cytoskeleton scaffold, and actin cross linker, localizing at stress fibers, focal adhesions, and other actin based structures. Palladin exists as multiple isoforms through alternative transcription initiation sites and splicing. There are three major isoforms (200, 140, 90-92 kDa) and multiple minor isoforms. Different palladin isoforms are expressed in a tissue-specific pattern during development and in adult organs: the 200 kDa isoform is predominantly expressed in the heart, skeletal muscle, testis and bone; the 140 kDa isoform is widely expressed with the exception of liver, muscle, and skin; the 90-92 kDa isoform is broadly expressed in embryonic tissues and highly expressed in adult smooth muscle tissues (21455759). Recently overexpression of palladin has been linked to the promoted invasive motility in several types of cancers (18978809, 22291919). The 85-90 kDa palladin isoform has been observed predominantly expressed in pancreatic ductal adenocarcinoma (PDA) while a 65 kDa isoform is expressed in normal pancreas and non-PDA tumors (20436683). This antibody, generated against the fragment 999-1383aa of palladin, recognizes most isoforms of this protein, except isoform 6.
实验方案
| Product Specific Protocols | |
|---|---|
| FC protocol for Palladin antibody 10853-1-AP | Download protocol |
| IF protocol for Palladin antibody 10853-1-AP | Download protocol |
| IHC protocol for Palladin antibody 10853-1-AP | Download protocol |
| IP protocol for Palladin antibody 10853-1-AP | Download protocol |
| WB protocol for Palladin antibody 10853-1-AP | Download protocol |
| Standard Protocols | |
|---|---|
| Click here to view our Standard Protocols |
发表文章
| Species | Application | Title |
|---|---|---|
Mol Cell The actin-bundling protein palladin is an Akt1-specific substrate that regulates breast cancer cell migration. | ||
Nat Commun Local microRNA delivery targets Palladin and prevents metastatic breast cancer.
| ||
Cell Death Differ lncRNA THAP7-AS1, transcriptionally activated by SP1 and post-transcriptionally stabilized by METTL3-mediated m6A modification, exerts oncogenic properties by improving CUL4B entry into the nucleus. | ||
Cancer Res Cofilin Drives Cell Invasive and Metastatic Responses to TGF-β in Prostate Cancer. | ||
Oncogene Twist1-induced activation of human fibroblasts promotes matrix stiffness by upregulating palladin and collagen α1(VI).
|